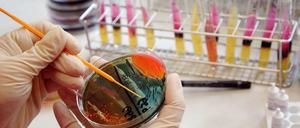

Unter dem Namen ihres Lehrers und der Adresse ihrer Schule haben zwei Schüler aus Hessen Computer und Zubehör im Wert von 3,6 Milliarden Euro im Internet geordert.
Hessen

Mit scharfen Angriffen auf die SPD und die Grünen fordert die neue Linke beim ersten gemeinsamen Bundesparteitag ihren Platz im Parteiensystem ein. Die Sozialdemokraten suchen derweil den richtigen Weg, mit der neuen Kraft von links umzugehen.

Der Staat kritisiert die Konzerne wegen der steigenden Preise, die Konzerne geben dem Staat die Schuld.
Die hessischen Parteien laufen sich warm für die Landtagswahl: Die Grünen wählen ihre Spitzenkandidaten, CDU und FDP beschwören dagegen die Gefahr eines rot-rot-grünen Bündnisses.
Die Zeit der Sommerfeste der Landesvertretungen ist gekommen, und jede „Außenstelle“ möchte die anderen mit Fetenideen übertrumpfen. Hessen hat sich schon mal an die Spitze katapultiert: „Wine in the sky“ nannte sich eine luftige Weinprobe, bei der zwei Dutzend Gäste samt Tisch hochhaushoch am Kran hängend die Tropfen vom Staatsweingut Kloster Eberbach probierten.

Warum Migranten Zeitungen lieber in ihrer Muttersprache lesen. Ein Redaktionsbesuch bei „Hürriyet“.
Berlin - Hessens Wirtschaftsminister Alois Rhiel (CDU) hat eine radikale Antwort auf die bundesweit drohenden Strompreisanhebungen: den Zwangsverkauf von Kraftwerken. Wenn es mehr Anbieter gibt, so die Überlegung des Ministers, dann muss es zwangsläufig auch mehr Wettbewerb geben – und der führt nach der Theorie des freien Marktes zu niedrigeren Preise.
In Teilen Deutschlands hat es am Samstag heftige Gewitter gegeben. Bei Blitzeinschlägen wurden insgesamt 27 Menschen verletzt.
Kein Disziplinarverfahren – Juristin hatte bei Scheidungsstreit auf Züchtigungsrecht des Mannes verwiesen
Wiesbaden - Als der hessische Umweltminister Wilhelm Dietzel (CDU) am vergangenen Montag Ministerpräsident Roland Koch (CDU) persönlich den Ausstellungstruck seiner Kampagne für erneuerbare Energien vorstellte, ahnte er bereits Unbill. Der Truck, der landesweit über Energien und Rohstoffe aus der Landwirtschaft informieren wird, trug die Aufschrift „Grüne Energie für Hessen“, Fahrzeug und Werbemittel prangten in Grün und Gelb, den Farben der politischen Konkurrenz.
Die umstrittene "Koran-Richterin" des Frankfurter Amtsgerichts muss nicht mit disziplinarischen Folgen rechnen. Sie hatte mit Verweis auf den Koran Gewalt gegen eine Ehefrau gerechtfertigt.
Andrea Ypsilanti beruft Bundestagsabgeordneten als Mann für Wirtschaft und Umwelt in Wahlkampfteam
Die Linkspartei will ihren West-Wahlerfolg in Hamburg wiederholen. Das wird nicht einfach
Parteien überbieten sich mit Ökologie-Konzepten
Vertriebenenverbände und der bayerische Ministerpräsident Stoiber dringen auf die Einrichtung eines Zentrums gegen Vertreibung. Außerdem nahm Stoiber die Sudetendeutschen gegen Kritik des tschechischen Staatschefs in Schutz.
Erneut haben Unwetter am Samstagabend in Teilen Deutschlands zahlreiche Schäden angerichtet. Betroffen waren vor allem Berlin, Rheinland-Pfalz, das Saarland und Hessen.
Die Gewerkschaft bereitet Kunden auf Einschränkungen beim Service vor. Auch der G-8-Gipfel ist im Visier von Verdi
Verdi will das Telekom-Management jetzt mit einem Streik in die Knie zwingen. Ab Freitag könnte das auch Konsequenzen für die Kunden des Konzerns haben.
Adolf Kunesch, 69, hat den DFB-Pokal der Frauen erschaffen, bleibt aber stets im Hintergrund. „Von mir gibt es nur Fotos im Familienalbum“, sagt er.
Hartmut Bäumer ist Verwaltungsreformer. Er weiß, was Landesbehörden zur effektiven Arbeit fehlt: Führungskraft und große Ziele
Hartmut Bäumer ist Verwaltungsreformer. Er weiß, was Landesbehörden zur effektiven Arbeit fehlt: Führungskraft und große Ziele
Bei seiner Asienreise hat Bundespräsident Köhler zuerst den vietnamesischen Staatspräsidenten besucht. Dabei kritisierte er Vietnams Umgang mit Dissidenten, rief aber auch zum Ausbau der Wirtschaftsbeziehungen auf.
Die Salmonellen-Infektionen am Klinikum Fulda sind vermutlich durch Lebensmittel ausgelöst worden. Die Zahl der Neuansteckungen hat sich mit fünf weiteren Patienten etwas verlangsamt.
Die Salmonellen-Infektionen am Klinikum Fulda sind vermutlich durch Lebensmittel ausgelöst worden. Die Zahl der Neuansteckungen hat sich mit fünf weiteren Patienten etwas verlangsamt.
Spaziergänger haben in einem leer stehenden Gebäude in Babenhausen in Hessen eine verbrannte Frauenleiche gefunden. Die Polizei geht davon aus, dass die Frau gewaltsam zu Tode kam.
Bei einem Schulbusunfall in Hessen sind 23 Menschen verletzt worden, 21 von ihnen Kinder. Beide Busfahrer schweben noch in Lebensgefahr.
Axel Sondermann stieg um: vom Konzernriesen zum Kurzstrecken-Marktführer, von Frankfurt nach Berlin. Jetzt leitet er Veolia
1:2 gegen Frankfurt: Bremen ohne Titelchance
1:2 gegen Frankfurt: Bremen ohne Titelchance
Wiesbaden - „Die Zeit ist reif für eine neue Politik.“ Unter dieser Überschrift hat die hessische SPD-Vorsitzende Andrea Ypsilanti ihren Programmentwurf für die „Zeit nach Koch“ vorgestellt.
Fabian und Tobias sind schwul. Das zuzugeben, war für den einen leicht – und für den anderen eine Tortur. Die Geschichte ihres Coming-outs.
Fabian und Tobias sind schwul. Das zuzugeben, war für einen leicht und für den anderen eine Tortur.
Im Streit mit der Telekom um den massiven Stellenumbau will Verdi das Management des Unternehmens jetzt mit einem Streik in die Knie zwingen: Privat- und Geschäftskunden des Konzerns müssen sich von diesem Freitag an auf Einschränkungen einstellen.
Von Caroline Fetscher
Schwerin - Kritisch wollen die acht Schüler aus Hessen, die Deutschland beim Junior-8-Gipfel in Wismar vertreten, im Juni in Heiligendamm den Staats- und Regierungschefs der G-8-Staaten schon gegenübertreten. Aber zur Großdemonstration in Rostock zieht es sie nicht.
Nach Wochen ungewöhnlicher Wärme steht eine Wetterwende bevor. Am Wochenende regnet es zwar nur im Süden Deutschlands. Von Montag an ist es dann aber auch im Norden vorbei mit dem Hochsommer im Frühling.
Im Tarifstreit der Metall- und Elektroindustrie hat die Warnstreikwelle ihren ersten Höhepunkt erreicht. Die Arbeitgeberseite signalisierte indes Entgegenkommen.
Auch Werke in Berlin und Brandenburg sind betroffen. Die Einigung wird erst Ende der Woche erwartet
Ein illegales Autorennen quer durch Europa ist in der Nacht zum Montag auf Deutschlands Autobahnen gestoppt worden. Fast 80 Fahrer wurden nach Polizeiangaben in Rheinland-Pfalz, Nordrhein-Westfalen und Hessen angehalten.
Dortmund siegt 2:0 gegen schwache Frankfurter